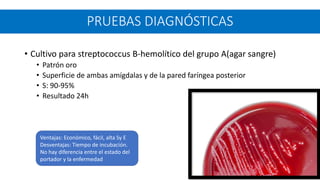
• Cultivo para streptococcus B-hemolítico del grupo A(agar sangre)
• Patrón oro
• Superficie de ambas amígdalas y de la pared faríngea posterior
• S: 90-95%
• Resultado 24h
PRUEBAS DIAGNÓSTICAS
Ventajas: Económico, fácil, alta Sy E
Desventajas: Tiempo de incubación.
No hay diferencia entre el estado del
portador y la enfermedad

Este documento describe la amigdalitis aguda, sus causas virales y bacterianas, y el diagnóstico y tratamiento. La amigdalitis bacteriana más común es por estreptococo del grupo A. Se recomienda el uso de los criterios de Centor para determinar el riesgo de infección y la necesidad de antibióticos. La penicilina es el tratamiento de elección para 10 días. La amigdalectomía solo se indica en casos de obstrucción de vías respiratorias u amigdalitis recurrentes.